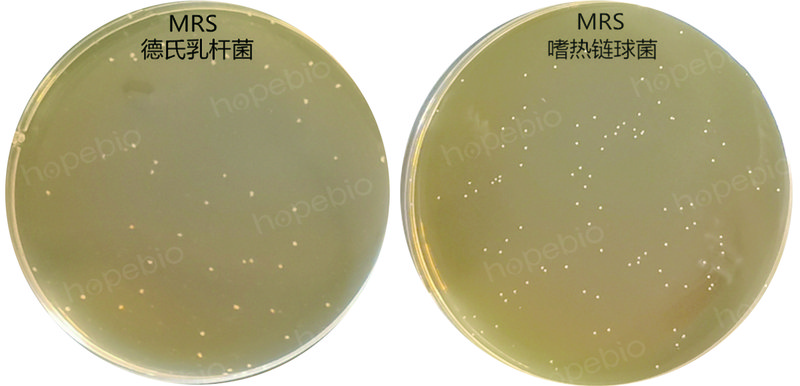

MRS琼脂培养基(GB4789.35-2023)/用于食品中乳酸菌的分离培养或计数


![]()
-
MRS琼脂/用于食品中乳酸菌的分离培养或计数
HB0384 | 见证书
-
MRS琼脂/用于食品中乳酸菌的分离培养或计数
HB0384 | 详见说明
-
MRS琼脂/用于食品中乳酸菌的分离培养或计数
HB0384 | 见证书
-
YM培养基
BNCC370527 | 见详情
-
R2A琼脂培养基
BNCC370559 | 见详情
-
802液体培养基
BNCC382695 | 见详情
-
S-23
1ST14533-5mg | 见证书
-
MRS琼脂/用于食品中乳酸菌的分离培养或计数
HB0384 | 见证书
-
MRS琼脂/用于食品中乳酸菌的分离培养或计数
HB0384 | 详见说明
-
MRS琼脂/用于食品中乳酸菌的分离培养或计数
HB0384 | 见证书
-
M2培养基
R32331-100ml | 见说明书
-
YM培养基
BNCC370527 | 见详情
-
MH液体试管
BNCC391763 | 见详情
-
中国蓝培养基即用型平板
BNCC391618 | 见详情
-
肉汤培养基G(麦康凯肉汤)
BNCC391158 | 见详情
-
EG肉汤培养基
BNCC390941 | 见详情
-
蛋白瘤胃球菌培养基基础(含纤维二糖)
BNCC389132 | 见详情




用途:用于食品中乳酸菌的分离培养或计数。
检验原理:
蛋白胨、牛肉膏粉、酵母膏粉提供氮源、维生素、生长因子;葡萄糖为可发酵糖类;磷酸氢二钾为酸碱缓冲剂;柠檬酸三铵、硫酸镁、硫酸锰、吐温-80 和乙酸钠为培养各种乳酸菌提供生长因子,其成分还能抑制某些杂菌并中和细胞毒性物质,为乳酸菌提供一个良好的生长环境;琼脂是培养基的凝固剂。
成分称取本品70.15g,加热煮沸完全溶解于1000ml蒸馏水中,分装,121℃高压灭菌15分钟,备用。
注:培养基中有少量的硫酸镁和硫酸锰,灭菌后可能出现微量沉淀。
MRS上德氏乳杆菌和嗜热链球菌的菌落形态:
MRS琼脂培养基微生物灵敏度试验: 按标签用法制备培养基,接种以下质控菌株,放置36±1℃厌氧培养48±2小时。以上信息仅供参考,请以实物批次为准!
本公司销售的所有产品仅供实验科研使用,不用于人体及临床诊断。
2. 分子生物学方法:新增实时荧光PCR作为选做方法,需使用DNA提取液、PCR缓冲液等试剂,提升检测灵敏度和特异性。
2. 使用含NaCl和胰蛋白胨的稀释液替代生理盐水,确保微生物活性。
3. 实验需同步进行阴性/阳性对照,验证培养基和试剂有效性。
2. 梯度稀释:采用10倍系列稀释法,选择2-3个适宜稀释度接种平板。
3. 培养条件:乳杆菌与双歧杆菌需厌氧培养(厌氧罐/培养箱),嗜热链球菌需需氧培养。
4. 结果判定:菌落形态观察结合生化试验(触酶、硝酸盐还原等)。
2. 设备精度要求:电子天平感量提升至0.001g,温度控制设备范围扩大至2-8°C。
3. 新增PCR方法适用范围:适用于快速筛查或争议结果复检,但不可替代培养法作为最终判定依据。
以上信息仅供参考,请以相应标准的原文为准!